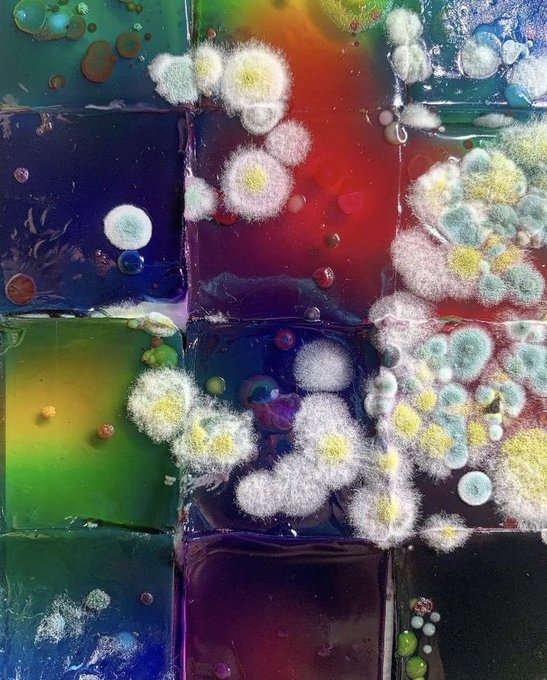

16 件中 1〜10件を表示
hello my dear friend has commissions open please consider helping him out!!! here are some examples of his art!!! https://t.co/8KGBJ5rET1
22
56